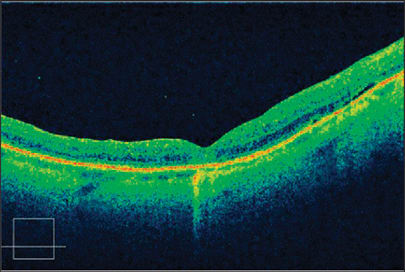

Settling the Debate on ILM Peeling in Macular Hole Surgery
The superior imagery of Cirrus HD-OCT may help determine the best ILM candidates.

By Paul E. Tornambe, MD
Macular holes are interesting phenomena. We don't know exactly why they develop or how they heal. But 95% of the time, we can surgically repair them successfully. Today, most retinal surgeons routinely peel the ILM as part of repairing a macular hole, because they believe that peeling the ILM improves surgical outcomes. Most physicians use dyes so they can see the ILM, although controversy surrounds their use because of potential toxic effects on the retina. Before the use of dyes, most surgeons didn't peel the ILM but still obtained about a 90% surgical success rate. In my opinion, doctors perform ILM peeling too frequently. The $64,000 question is, which eyes are the best candidates for ILM peeling and which eyes are not?
In most cases, I believe that simply removing the posterior hyaloid (PH) from the ILM over the macula closes the macular hole successfully. In my experience, macular holes fail to close when PH tissue remains on the ILM. The Stratus OCT has demonstrated that a schisis (splitting) of the PH can occur (Figure 1). Sometimes the outer posterior wall of the schisis remains on the ILM when the PH separates. This PH remnant may exert tangential traction on the hole and prevent it from closing, or it may reopen the hole later. When you peel the ILM, you remove the overlying remnant of the PH tissue schisis. This is analogous to napkins (PH remnant) on a tablecloth (ILM). Removing the tablecloth also removes the napkins. But if there are no napkins on the tablecloth, removing the tablecloth isn't necessary.

Figure 1. The Stratus OCT shows a schisis of the posterior hyaloid in a patient with vitreomacular traction syndrome.
My early experience with Cirrus HD-OCT suggests that it may be possible to image these PH remnants. Recognizing PH remnants pre-op may permit surgeons to target this area of the ILM and remove the overlying PH. In addition, if Cirrus HD-OCT shows that the PH has separated from the macular area and no PH tissue remains on the ILM, the surgeon may decide not to peel the ILM. This level of detail, not available with Stratus OCT, is possible because of the dense scan data acquired by Cirrus HD-OCT.
ILM Peeling Required
A 57-year-old woman presented with an early stage II macular hole. I injected a 100% 0.5 cc SF6 gas bubble into her vitreous cavity to sever the adhesion of the PH from the macula, thereby releasing the traction on the hole. The injected bubble released the PH attachment from the fovea (Figure 2). The patient lay face down for 5 days; however, the hole didn't close. Why didn't the hole close? A virtual angiographic C-scan from Cirrus HD-OCT demonstrated that the PH schisis tissue remained on the surface of the retina, exerting tangential traction — which may have prevented the hole from closing (Figure 3). The patient underwent conventional macular hole surgery with ILM peeling, and the hole closed (Figure 4). The PH tissue lying on the ILM on inferior macula was removed with the ILM. Cirrus HD-OCT even revealed where I removed the ILM (Figure 5).

Figure 2. This B-scan shows a post-pneumatic separation of the posterior hyaloid (PH). The Cirrus HD-OCT high-resolution horizontal raster scan through the center of the macular hole shows that the PH has separated from the ILM. And in this B scan section, there's no residual PH tissue on the ILM. The five high-resolution horizontal raster scans normally don't image the area outside the central macula. In this case, the PH schisis tissue lies inferior to the hole and is imaged only by a portion of the lower resolution 200 B-scans (see Figure 3).

Figure 3. A virtual angiography C-scan from Cirrus HD-OCT shows a post-pneumatic separation of the posterior hyaloid (PH) in the right eye. A large placoid remnant of the PH is noted on the IN macula adjacent to the macular hole, following pneumatic displacement of the PH. The horizontal high-resolution raster scan in Figure 2 usually doesn't show this area, because the tissue is inferior to it. However, the Cirrus HD-OCT 3D scan routinely images this area.
Figure 4. This is a high-resolution raster scan from Cirrus HD-OCT 1 week following successful macular hole surgery with ILM peeling. The patient received a 25% SF6 gas bubble injection and didn't require face-down posturing.

Figure 5. This is a high-resolution C-scan from Cirrus HD-OCT following successful macular hole surgery with ILM peeling. Note that the PH remnants in Figure 3 aren't present in the area inferior to the now-closed hole. The star-shaped area (shown here) represents a defect in the ILM where it was peeled.
When removing retinal tissue, most surgeons know that less usually is better. Choosing not to peel the ILM in all cases of macular hole surgery may result in decreased OR time and better visual outcomes. If Cirrus HD-OCT can determine if PH tissue is present on the retinal surface preoperatively, it may help physicians decide whether or not to peel the ILM. The six diagonal B-scans created by Stratus OCT don't reveal the PH tissue on the ILM, which is elegantly demonstrated by the 200 horizontal B-scan images of Cirrus HD-OCT.
Cirrus HD-OCT provides unique images of the inner retinal surface, which are helpful clinically for surgical assessment planning. The technology may help identify patients who will benefit from ILM peeling in macular hole surgery, and those who would not benefit from it. OM








